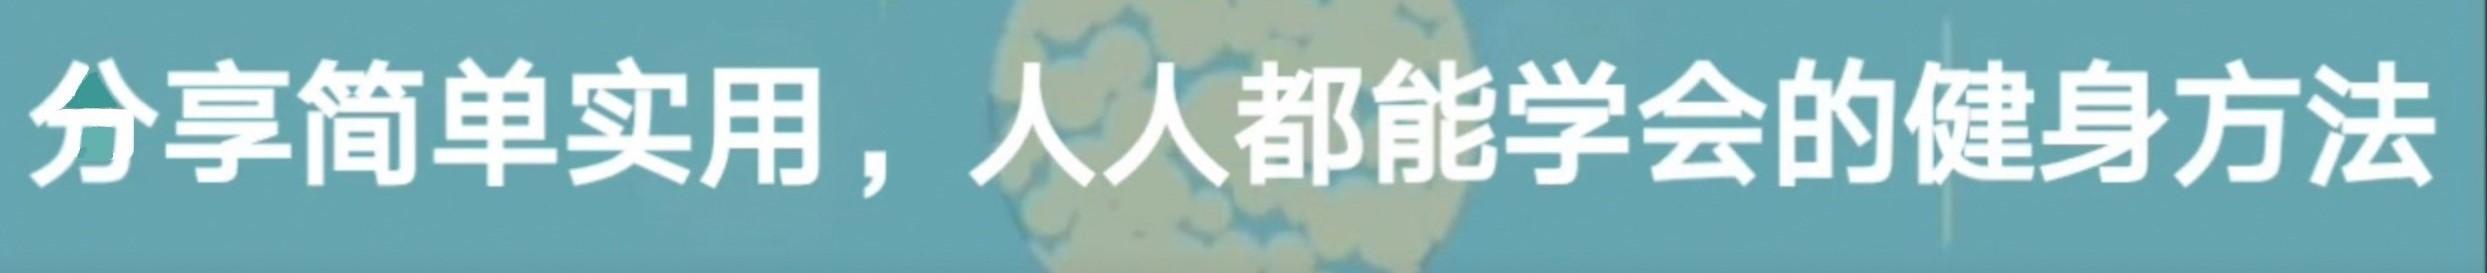

掌握好哑铃飞鸟的4个小细节,让你的胸肌训练更加安全高效
掌握好哑铃飞鸟的4个小细节,让你的胸肌训练更加安全高效
哑铃占地面积小,使用起来灵活方便,可以锻炼全身各部位肌肉,是居家健身最实用的工具之一。对于胸肌的锻炼来说,哑铃有各种角度的推举和飞鸟动作。如果说哑铃推举是打造胸肌厚度的主打动作的话,那么哑铃飞鸟就是发展胸肌宽度的王牌动作。掌握好哑铃飞鸟,绝对会让你的胸肌又大又宽!今天,我们就以平板哑铃飞鸟这个动作为例来聊聊其中最值得注意的4个小细节。

平板哑铃飞鸟
本文将为你提供以下信息:
哑铃飞鸟的动作原理哑铃飞鸟的基本动作步骤哑铃飞鸟的4个小细节
一、哑铃飞鸟的动作原理

肩水平内收
哑铃飞鸟这个动作主要利用的是胸大肌和三角肌前束的肩水平内收的功能,它的运动轨迹呈两个大的弧形,看上去类似鸟类扇动翅膀的样子,因此而得名。
二、哑铃飞鸟的基本动作步骤

哑铃飞鸟的运动轨迹
身体放松平躺在窄凳上,双脚平稳的踩在地面上,保证肩部自由活动,手持哑铃双臂向上伸直,双臂保持略微弯曲。吸气,两臂张开平稳下滑,使肘与肩同高。呼气的同时上举哑铃至初始位置,要找到一种环抱水桶的感觉。
三、哑铃飞鸟的4个小细节
哑铃飞鸟这个动作有许多需要注意的小细节,其中有4个方面最值得大家关注。
1.保持肩胛骨稳定
哑铃飞鸟是一个单关节动作,肩胛骨保持稳定,可以使动作质量更好,让胸大肌的受力最大化。在具体的动作过程中,我们需要注意两方面:
①避免耸肩

想象我是躺在平凳上,从上往下看,斜方肌是耸起来的
有些朋友在练哑铃飞鸟时容易耸肩,耸肩时斜方肌分担了胸肌的受力,从而降低了锻炼效果,还容易引发肩关节的损伤。
造成耸肩的原因主要有两点,一是使用的重量太大,超出了自身的能力范围;二是由于长期的不良站姿和坐姿,造成上部斜方肌和肩胛提肌过于活跃、中下斜方肌和菱形肌拉长无力的肌肉状态。
对于前一种原因,改善的方法很简单,就是直接减轻哑铃的重量,将重量控制在自己的能力范围之内,这样就会避免上部斜方肌代偿。
而对于第二种原因,我们需要在正式的锻炼之前先去放松紧张僵硬的上部斜方肌和肩胛提肌、再去激活菱形肌和中下斜方肌。

拉伸上部斜方肌
拉伸上部斜方肌动作要领:坐在平凳上,脊柱保持中立,将左手掌压在臀部下,以帮助左侧肩胛骨保持下沉和稳定,右手掌放在头部左侧向右侧轻轻拉伸;左右交替各拉伸20~30秒钟。

拉伸肩胛提肌
拉伸肩胛提肌动作要领:坐在平凳上,脊柱保持中立,将左手掌压在臀部下,以帮助左侧肩胛骨保持下沉和稳定,先收下巴再低头,将头轻轻转向右边,视线朝右下方,右手掌放在头部左后侧向右侧轻轻拉伸;左右交替各拉伸20~30秒钟。
对菱形肌和中下斜方肌的激活,我们可以采用常见的"TYW"训练法。

“TYW”训练
动作要领:双腿分开与髋同宽,上半身略前倾,背部挺直,腹部核心收紧,双臂分别呈"TYW"形从前向后伸展。将注意力集中在肩胛骨内侧,每个动作做15次,做2~3组。
此外,需要注意的是,单单依赖健身并不能治本,我们在平时的生活中要多注意观察自己的体态,及时调整不良的站姿和坐姿,慢慢的才会有所改善。因为我们生活中大部分时间都是坐着的,健身的时间还是比较少。当我们工作学习30分钟左右后就应该起身活动活动,放松一下肩关节周围的肌肉群,以避免长时间保一个姿势所造成的肩颈部肌肉紧张僵硬。
②避免含胸

想象我是躺在平凳上,从侧面看,在哑铃举到最高点时出现含胸
有些健身爱好者喜欢做大幅度的飞鸟动作,在哑铃举到胸部上方时含胸去挤压胸大肌。在健美训练中强调顶峰收缩的想法没错,但是对哑铃飞鸟来说,这种含胸的方式并没有什么效率。
首先,哑铃举到胸部上方时并不需要将哑铃触碰到一起。在哑铃飞鸟这个动作中,因为杠杆原理,哑铃离身体中心线越远,胸大肌的受力越大,哑铃离身体中心线越近,胸大肌的受力越小。当两个哑铃触碰在一起的时候,哑铃的重力和胸大肌的起点——胸骨、胸锁关节处于一条直线上,胸大肌的受力就几乎没有了,我们甚至可以在这个时候放松胸大肌,只靠手臂支撑住哑铃。

哑铃离身体中心越远,胸肌受力越大,反之亦然
其次,如果习惯含胸做动作,久而久之容易使胸肌深层的胸小肌缩短和紧张,造成含胸驼背的不良体态。

呈锯齿状的是前锯肌,闪动的肌肉就是胸小肌。胸小肌是一块不需要过多强化的肌肉
所以,更好的方式是,在保证肩胛骨下沉、后缩的前提下再去强调胸大肌的顶峰收缩。在哑铃举到最高处时,保持沉肩、挺胸,双臂努力向中间夹,但不要将两个哑铃触碰在一起。
2.将肩关节适度内收
有些朋友在练哑铃飞鸟时,双肘抬得过高,有的甚至超过了肩关节。这种姿势不但容易造成肩袖肌群损伤,而且也使得三角肌前束受力增大,减小了胸大肌的受力。
更好的方式是,将双臂和身体之间的角度保持在60~75°左右。这样的姿势可以使胸大肌受力更好,同时也会大大降低肩袖肌群受伤的概率。

肩关节过于外展和适度内收的对比图
有些资深的健身者有时也会刻意练习肩关节外展角度比较大的飞鸟动作,这是在基于他们良好的肩部柔韧性和肌肉控制能力的基础之上的,并不适用于大多数健身爱好者,特别是健身新手。
3.限制"扇翅膀"的幅度
理论上来说,在离心收缩阶段,为了更好的拉伸胸大肌,双臂应该尽量向下放,但是在现实生活中,很多人肩部的柔韧性并不是很好,而且当胸大肌过度伸展以后,胸大肌的张力将会降低,这时施加在肩关节上的压力就会变得很大,这样就增加了肩关节和肩袖肌群的受伤几率。

胸大肌过度伸展
所以,更为安全有效的方式是,在离心收缩阶段,我们要在自己的肩部柔韧性的能力范围之内去拉伸胸大肌,不要盲目去模仿别人的动作。一般来说,从侧面看,当肘关节、肩关节和躯干几乎处于一条直线时,胸大肌就已经有一个比较强烈的拉伸感了。当然了,具体的拉伸幅度还是应根据个人的能力来灵活掌握。

肘关节、肩部和躯干几乎处于一条直线
4.留意肘关节的角度
对于这一点,常见的误区有两种,一是肘关节伸得过直,二是肘关节屈曲得过多。
在动作的离心阶段,当肘关节伸得过直时,哑铃到肩关节的水平距离就会增大,力臂增大,力矩就会变大,随之而来的便是肘关节和肩关节的压力增大,而关节压力过大就容易引发这两个部位出现损伤。

肘关节角度过大
当肘关节角度过小,甚至形成90°时,肩关节和肘关节的压力虽然减小了,但是这时候动作却变成了另一个动作——哑铃推举。而且,在向心收缩的过程中,手肘如果弯曲,这会使得肩膀无法向内靠近,导致肩水平内收幅度不足,胸大肌也就不能达到更完整的收缩。

肘关节角度过小
所以,正确的方式是:在动作的离心阶段,双肘应该屈曲成130°左右,这样既可以充分拉伸胸大肌,也不会使肩、肘关节压力过大;在动作的向心阶段,双臂应逐渐接近伸直并努力靠近,这样才能完成肩水平内收动作,更充分的挤压胸大肌。

肘关节微屈
结束语

哑铃飞鸟作为一个单关节动作,可以放在胸部训练的最后阶段来榨干胸肌,也可以放在胸部训练的开头来激活胸肌,只要你掌握了以上4个小细节,一定会使你的训练水平更上一个台阶!
如果觉得本文有帮助到你,欢迎转发点赞,以帮助更多人避免运动误区,同时也欢迎你的评论和关注,谢谢!
#宅家也运动#
标签:


















